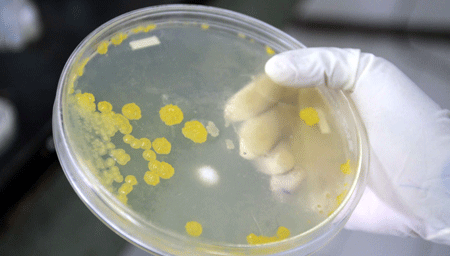

| Año 8 • No. 321 • Agosto 18 de 2008 | Xalapa • Veracruz • México |
Publicación
Semanal
|
![]()
Centrales
Editorial
General
Reportaje
Regiones
Becas
y oportunidades
Arte
Deportes
Contraportada
|
||
Destaca
microbiología por trabajar |
||
|
El
plástico biodegradable podría sustituir al sintético,
que tarda un siglo en degradarse
Al fijar el nitrógeno en las plantas se reduce el uso de fertilizantes químicos que dañan la salud y el ambiente Se trabaja en una solución para los habitantes que ingieren agua contaminada de los manantiales de Banderilla |
||
| La
Universidad Veracruzana (UV) es una institución que además
de estar comprometida con la sociedad al proporcionar una formación
integral a los jóvenes que ingresan a sus aulas cada año,
también tiene el compromiso de mejorar el medio ambiente a
través de la generación y aplicación del conocimiento. Por tal razón, el Instituto de Investigaciones Biológicas (IIB), a través del laboratorio de Microbiología, incentiva y apoya el trabajo de jóvenes de licenciatura para que desarrollen proyectos de investigación que de alguna manera repercutan en el ambiente y en la población. Silvestre Augusto Hernández Rivera, responsable del Área, informó que en este laboratorio se han desarrollado proyectos importantes como la creación de biodiesel a partir de aceites vegetales y animales utilizados para freír alimentos, como antojitos y hamburguesas. El aceite comestible después de haber pasado por un proceso químico, puede ser utilizado en vehículos sin peligro de que genere plomo o algún contaminante dañino para el ambiente y para el ser humano, comparable con el que generan los derivados del petróleo. La creación del biodiesel llevó a la UV a ser la primera universidad del sureste en desarrollar el combustible y comprobar su utilidad; asimismo, se realizaron extractos de plantas con fines antibacteriales y otros para disminuir los niveles de azúcar en la sangre. Después de varios años de trabajo con los jóvenes, el académico aseguró que los estudiantes están mejor preparados para trabajar en el laboratorio y enfrentarse al campo laboral, pues generan conocimientos y buscan su aplicación en beneficio de la sociedad a través de su servicio social o la realización de su trabajo recepcional. Actualmente, tres egresadas de la licenciatura de Biología trabajan para desarrollar proyectos encaminados a aislar bacterias capaces de producir plásticos biodegradables, reproducir otras que pueden contribuir en la fijación biológica de nitrógeno en plantas y analizar los contaminantes del agua de los manantiales de Banderilla. |
||
 Una vez que se forman nódulos en las plantas, se obtienen cepas bacterianas de Rhizobium |
Crean
plástico biodegradable Con base en su compromiso como universitaria de trabajar para mejorar el medio ambiente, Elizabeth Ortiz García, egresada de la Facultad de Biología, desarrolla su trabajo recepcional cuyo fin es aislar bacterias potencialmente capaces de producir polímeros que reemplacen los productos elaborados con plástico sintético. Es tal la trascendencia de la investigación, que el medio ambiente se verá beneficiado al no degradar plásticos sintéticos que tardan hasta 100 años en desintegrarse. Aunque esta afirmación es temprana porque aún no se ha concluido el proyecto, tiene una gran perspectiva porque es una opción viable para reemplazar la utilización de derivados del petróleo. |
|
| Elizabeth
Ortiz, quien trabaja en el área de Microbiología, comentó
que su trabajo consiste en obtener, aislar y caracterizar cepas potencialmente
productoras de Polißhidroxialcanoatos (PHA), polímero
cuya característica es ser biodegradable en ecosistemas diversos
y no contaminar. Informó que las cepas las obtiene de muestras
de suelo, provenientes de plantaciones de plátano, tabaco,
sandía y jitomate. Explicó que los PHA son almacenados como gránulos intracelularmente en una gran variedad de bacterias como material de reserva y energía. Detalló que para que se lleve a cabo la síntesis de estos polímeros, debe ser bajo condiciones de crecimiento no balanceado, como pueden ser la ausencia de nitrógeno, magnesio y fósforo y un exceso en la fuente de carbono. Ortiz García aseguró que es muy difícil llegar con éxito a la obtención de cepas bacterianas capaces de producir Polißhidroxialcanoatos, pues se deben realizar muchas pruebas previas. Luego que la idea inicial del proyecto surgió como una aportación para mejorar el medio ambiente, trabaja diariamente en el laboratorio para crear conocimiento y compartirlo con la sociedad. Una vez que haya identificado las bacterias que producen los PHA realizará su caracterización bioquímica; asimismo, hará una valoración de diferentes fuentes de carbono, entre otras de glucosa, sacarosa y la melaza, en especial de esta última pues es de bajo costo y fácil de adquirir. Cabe mencionar que hasta el momento se sabe poco sobre el uso de la melaza, que es una azúcar no refinada y con muchos elementos. |
||
 La fijación de nitrógeno se estudia en plantas leguminosas Macroptilium atropurpureum |
Fijan
nitrógeno en las plantas Yanneth García Cabrera, también egresada de Biología, trabaja para aislar bacterias de Rhizobium y así favorecer la fijación de nitrógeno en plantas leguminosas Macroptilium atropurpureum. Dio a conocer que su investigación puede traer como resultado la disminución en el uso de fertilizantes nitrogenados tradicionales que contaminan en gran medida el ambiente. Incluso, dijo, se detectó que se alcanzan niveles de concentración muy altos, por su arrastre lejos de las plantas a las que se les proporcionan, llegando a ríos o penetrando el subsuelo y contaminando los mantos freáticos, hasta llegar al humano. |
|
| Del
total del fertilizante que se le proporciona por abono, sólo
aprovecha cerca de 40 por ciento. Se reportaron algunos casos de enfermedades
en lactantes por la eutrofización, que alcanza niveles elevados
en las aguas que han sido consumidas por madres que amantan a sus
hijos. Cabe destacar que en el ambiente existe una gran cantidad de nitrógeno que va de 78 a 83 por ciento y que la planta no puede aprovechar, precisamente por la incapacidad de romper el enlace que une a las dos moléculas de nitrógeno. Algunas acciones que contribuyen a liberar las moléculas del nitrógeno son las descargas eléctricas causadas durante las tormentas y otros aportes son mediante los procesos fisiológicos de los animales como la orina. Sin el nitrógeno la planta no podría producir sus aminoácidos y formar sus proteínas. Interesada en este proceso, Yanneth García colectó la leguminosa Macroptilium atropurpureum en La Mancha, con el propósito de obtener nódulos y de ahí las cepas bacterianas de Rhizobium. Después de elegir los nódulos con mejor apariencia y color, los maceró; del extracto obtenido se sembró una muestra en placas de agar YEM y siguió un procedimiento para conservación y uso posterior para inocular plántulas obtenidas por siembra en invernadero, con el fin de conocer su capacidad invasora en la planta. Detalló que la leguminosa presenta flores pequeñas de color púrpura. Estas plantas tienen una asociación simbiótica con las bacterias del género Rhizobium; existe evidencia de que las plantas exudan ciertas sustancias que facilitan que las bacterias puedan infectar la planta y formar en la raíz de la planta los nódulos. La bacteria tiene la capacidad de “cortar” los enlaces del nitrógeno por los que se encuentran unidas las moléculas de nitrógeno, para que la planta pueda obtenerlo con facilidad y formar sus aminoácidos y posteriormente sus propias proteínas. A cambio, la planta le da nutrientes y hospedaje para que subsista. Después de un tiempo, cuando la planta da inicio a la floración y fructificación, la bacteria sale de los nódulos que empiezan a morir y se mantiene un buen número de ellas en vida libre, hasta que llega el siguiente ciclo y vuelva a invadir a la planta. Veracruz tiene al menos 600 especies de leguminosas silvestres que pueden ayudar a fertilizar los suelos y así disminuir el uso de derivados de petróleo para los agroquímicos. Por ello es importante este proyecto de investigación, además que se genera conocimiento con un impacto social. |
||
El
trabajo de Elizabeth Ortiz consiste en obtener y caracterizar
cepas |
||
|
Contaminación
en manantiales de Banderilla |
||
|
|
||
|
||

